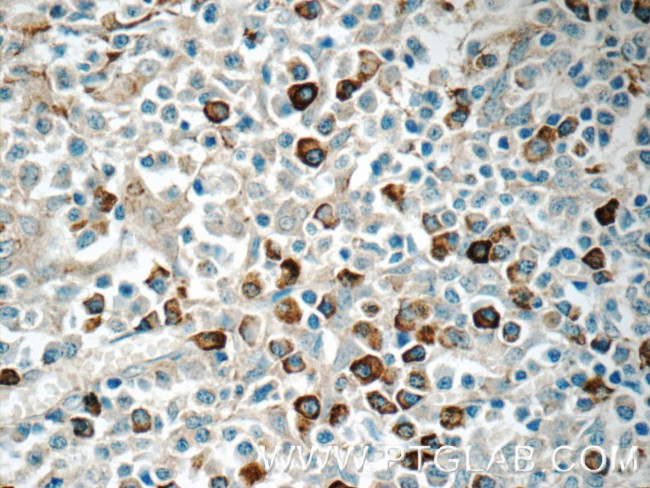
TRA Antibody in Immunohistochemistry (Paraffin) (IHC (P))

Search
Proteintech
TRA Polyclonal Antibody
{{$productOrderCtrl.translations['antibody.pdp.commerceCard.promotion.promotions']}}
{{$productOrderCtrl.translations['antibody.pdp.commerceCard.promotion.viewpromo']}}
{{$productOrderCtrl.translations['antibody.pdp.commerceCard.promotion.promocode']}}: {{promo.promoCode}} {{promo.promoTitle}} {{promo.promoDescription}}. {{$productOrderCtrl.translations['antibody.pdp.commerceCard.promotion.learnmore']}}
产品信息
11890-1-AP
种属反应
宿主/亚型
分类
类型
抗原
偶联物
形式
浓度
规格
纯化类型
保存液
内含物
保存条件
运输条件
产品详细信息
Immunogen sequence: MQRISSLIH LSLFWAGVMS AIELVPEHQT VPVSIGVPAT LRCSMKGEAI GNYYINWYRK TQDIQNPDPA VYQLRDSKSS DKSVCLFTDF DSQTNVSQSK DSDVYITDKT VLDMRSMDFK SNSAVAWSNK SDFACANAFN NSIIPEDTFF PSPESSCDVK LVEKSFETDT NLNFQNLSVI GFRILLLKVA GFNLLMTLRL WSS (1-202 aa encoded by BC020840)
靶标信息
The T cell antigen receptor (TCR) consists of a ligand-specific alpha/beta heterodimer non-covalently associated with five invariant chains including the CD3 gamma/delta/eta and zeta subunits, all of which are required for efficient surface expression. T cell activation through the TCR induces cellular differentiation and/or proliferation and the production of lymphokines and cytokines. Both the CD3 and TCR zeta subunits are proposed to be responsible for the intracellular signal transduction events. Majority of T cells present in the blood, lymph and secondary lymphoid organs express TCR alpha/beta heterodimers, whereas the T cells expressing TCR gamma/delta heterodimers are localized mainly in epithelial tissues and at the sites of infection. The subunits of TCR heterodimers are covalently bonded and associate with the CD3 subunits in the endoplasmic reticulum to form functional TCR-CD3 complex. Lack of expression of any of the chains is sufficient to stop cell surface expression. The ability of T cell receptors (TCR) to discriminate foreign from self-peptides presented by major histocompatibility complex (MHC) class II molecules is essential for an effective adaptive immune response. TCR recognition of self-peptides has been linked to autoimmune disease. Mutant self-peptides have been associated with tumors. Engagement of TCRs by a family of bacterial toxins know as superantigens has been responsible for toxic shock syndrome. Autoantibodies to V beta segments of T cell receptors have been isolated from patients with rheumatoid arthritis (RA) and systemic lupus erythematosus (SLE). The autoantibodies block TH1-mediated inflammatory auto-destructive reactions and are believed to be a method by which the immune system compensates for disease (ref5). T Cell and TCR Diversity Most human T cells express the TCR alpha-beta and either CD4 or CD8 molecule (single positive, SP). A small number of T cells lack both CD4 and CD8 (double negative, DN). Increased percentages of alpha-beta DN T cells have been identified in some autoimmune and immunodeficiency disorders. Gamma-delta T cells are primarily found within the epithelium. They show less TCR diversity and recognize antigens differently than alpha-beta T cells. Subsets of gamma-delta T cells have shown antitumor and immunoregulatory activity.
仅用于科研。不用于诊断过程。未经明确授权不得转售。
篇参考文献 (0)
生物信息学
蛋白别名: FLJ22602; MGC117436; MGC22624; MGC23964; MGC71411; t-cell antigen receptor; T3/TCR complex; tcr alpha; TCR alpha/ beta; TCR beta
基因别名: IMD7; TCRA; TRA; TRCA
Entrez Gene ID: (Human) 28755